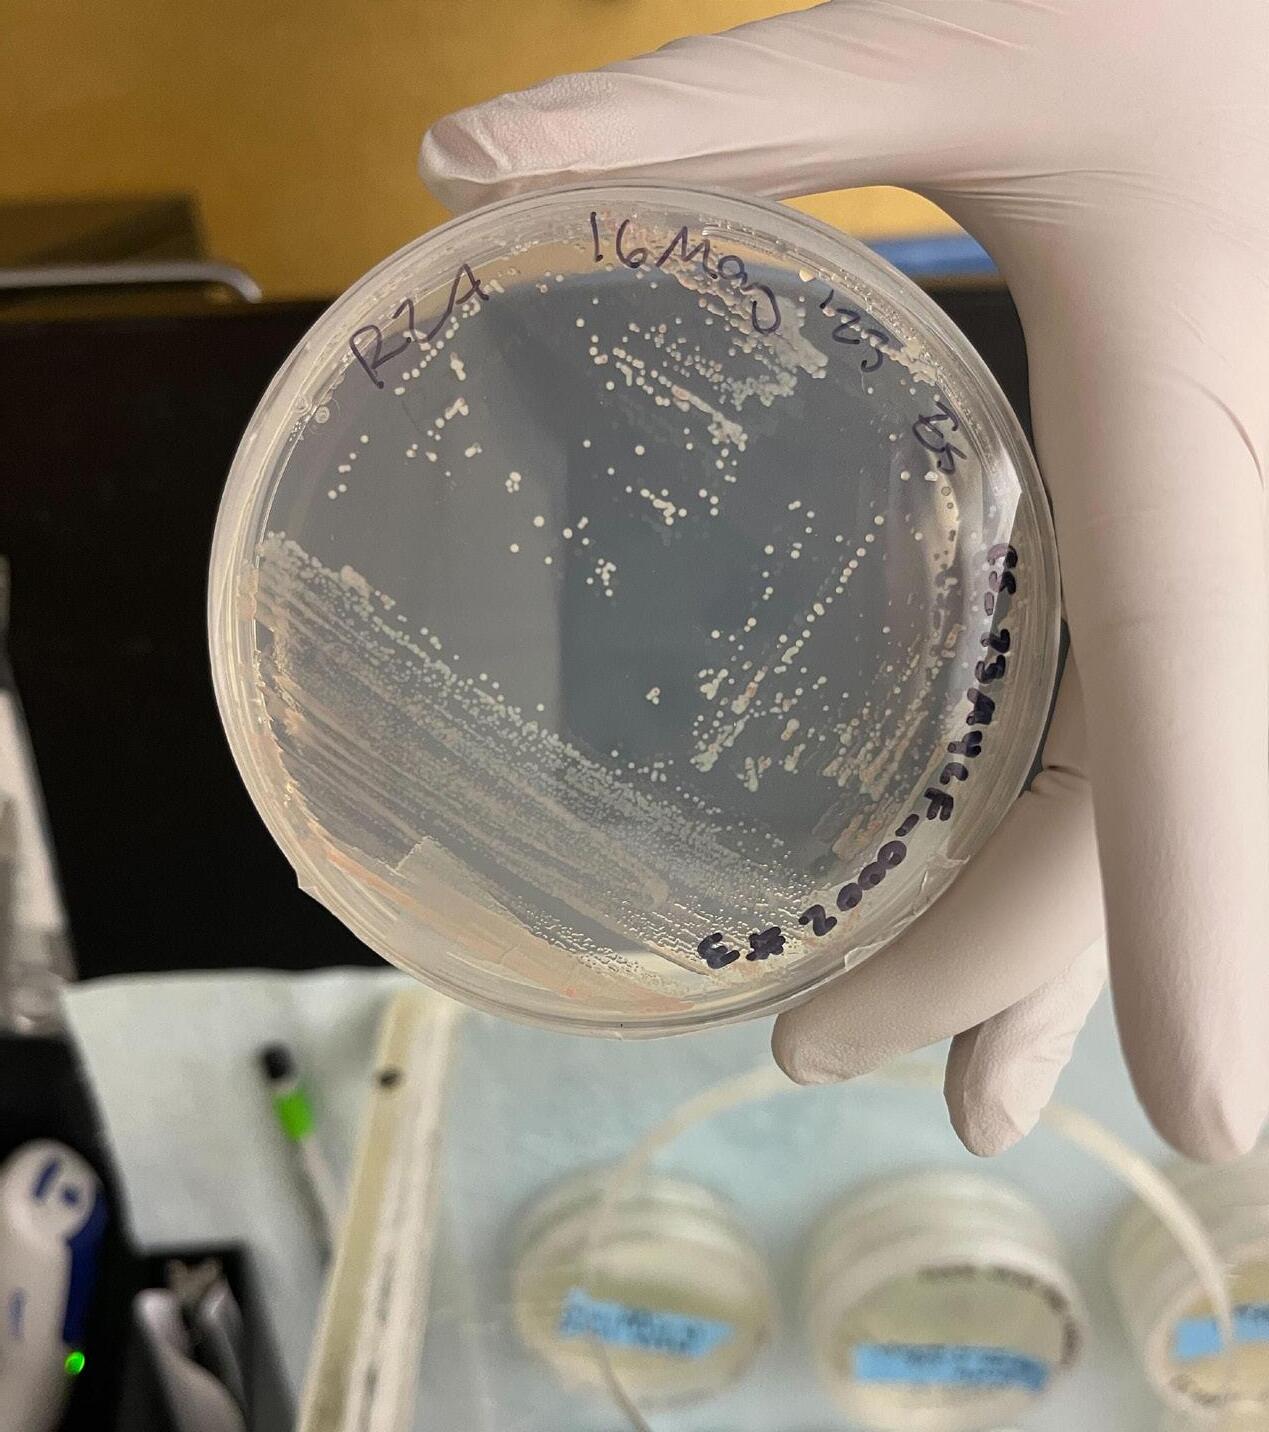

JOURNAL
The Southwest: Protecting Local Wildlife Species

SEPTEMBER/OCTOBER 2023
October is Kids Free month at the San Diego Zoo and San Diego Zoo Safari Park, when youths 11 years and younger receive free admission all month long (with an adult). Youths can connect with their wild side by meeting wildlife, while discovering the wonders of nature through play and exploration. Come connect with nature at Wildlife Explorers Basecamp at the San Diego Zoo!
sdzwa.org/kidsfree









Journey Through Our Conservation Work This issue of the San Diego Zoo Wildlife Alliance Journal focuses on the Southwest hub. To learn more about our collaborative conservation programs around the world, including our wildlife care at the San Diego Zoo and San Diego Zoo Safari Park, visit sdzwa.org.
Amazonia Jaguar Asian Rainforest Tiger Savanna Elephant & Rhino Pacific Islands ‘Alalā Australian Forest Platypus & Koala
10
Contents
2 President/CEO’s Letter
3 By the Numbers
4 Findings
6 Meet Our Team
8 Hot Topics
26 Events
28 Wildlife Explorers Page

29 Last Look
Cover Story
10
More Than Skin Deep
Following decades of research, scientists uncovered clues and have solved the mystery surrounding population loss among mountain yellow-legged frogs.

Features
16
Growing Together

As part of SDZWA’s Native Biodiversity Corps, local students are discovering the importance of collaboration and teamwork in wildlife conservation.
20
Generating Hope
Regenerative medicine is proving to be a vital new therapeutic tool, offering vast new possibilities in veterinary care.
24
Visualize It
On the Cover: Mountain yellow-legged frog Rana muscosa. Photo by: Ken Bohn,SDZWA photographer
As fanciful as butterfly migration may seem, there is a science behind these winged wonders’ flight patterns. 16 20
African Forest Gorilla September/October 2023 Vol. 3 No. 5
Southwest Desert Tortoise & Burrowing Owl Oceans Polar Bear & Penguin
PHOTOS
BY:
(TOP, BOTTOM) KEN BOHN/SDZWA, (MIDDLE) SDZWA
SENIOR EDITOR Peggy Scott STAFF WRITERS
Donna Parham
Elyan Shor, Ph.D.
Alyssa Leicht
COPY EDITOR Eston Ellis
DESIGNER Christine Yetman
PHOTOGRAPHERS
Ken Bohn
Tammy Spratt
DESIGN AND PRODUCTION

Kim Turner
Lisa Bissi
Jennifer MacEwen
PREPRESS AND PRINTING Quad Graphics


Let's Stay Connected
Follow @sandiegozoo & @sdzsafaripark.
Share your #SanDiegoZoo & #SDZSafariPark memories on Twitter & Instagram.
The Zoological Society of San Diego was founded in Octo ber 1916 by Harry M. Wegeforth, M.D., as a private, nonprofit corporation, which does business as San Diego Zoo Wildlife Alliance.

The printed San Diego Zoo Wildlife Alliance Journal (ISSN 2767-7680) (Vol. 3, No. 5) is published bimonthly, in January, March, May, July, September, and November. Publisher is San Diego Zoo Wildlife Alliance, located at 2920 Zoo Drive, San Diego, CA 92101-1646. Periodicals postage paid at San Diego, California, USA, and at additional mailing offices. POSTMASTER: Send address changes to San Diego Zoo Wildlife Alliance, P.O. Box 120271, San Diego, CA 92112-0271.
Copyright© 2023 San Diego Zoo Wildlife Alliance. All rights reserved. All column and program titles are trademarks of San Diego Zoo Wildlife Alliance. If your mailing address has changed: Please contact the Membership Department; by mail at P.O. Box 120271, San Diego, CA 92112, or by phone at 619-231-0251 or 1-877-3MEMBER.
For information about becoming a member of San Diego Zoo Wildlife Alliance, please visit our website at ZooMember.org for a complete list of membership levels, offers, and benefits.
Subscriptions to San Diego Zoo Wildlife Alliance Journa l are $25 per year, $65 for 3 years. Foreign, including Canada and Mexico, $30 per year, $81 for 3 years. Contact Membership Department for subscription information.
A Journey Through Conservation in the Southwest

As a global conservation organization that aims to create a world where people, wildlife, and ecosystems thrive together, we approach our work knowing that the hope woven throughout conservation can inspire a lifetime of change. We are fortunate to call the Southwest home, and we see daily reminders all around us of the wonder that exists in the most biodiverse county in the contiguous United States. In this issue of the San Diego Zoo Wildlife Alliance Journal , we’ll explore how our Alliance’s leadership starts right here in our own backyard, and how together we can create a transformative impact through conservation.
For over 107 years, the San Diego Zoo and San Diego Zoo Safari Park have been at the forefront of our conservation efforts. Today, these two leading zoos serve as the epicenters of our work, enabling us to further develop our expertise in wildlife care and veterinary science, which we now share far beyond our two front doors. Every day, our teams of dedicated wildlife care specialists and conservation scientists work to launch new techniques to provide the highest standard of care, create new opportunities for conservation, and share sustainable solutions to the challenges facing wildlife with our partners around the world.
In this issue, you’ll discover some of these groundbreaking conservation opportunities. With you by our side, we are pioneering regenerative medicine technologies in veterinary care, combating illegal wildlife trafficking on the front lines, initiating conservation efforts for endangered species, and inspiring the next generation of conservation leaders, right here in San Diego.
Your contributions, both big and small, serve as a driving force behind our work. We are honored and grateful to have a community of wildlife champions who share our passion for inspiring positive change.
We look forward to seeing you at the San Diego Zoo and the San Diego Zoo Safari Park, where you can experience your next life-changing moment and connect with the world’s wildlife. Every visit makes a difference for wildlife, and together we can help create a world where all life thrives.
As part of San Diego Zoo Wildlife Alliance’s commitment to conservation, this magazine is printed on recycled paper that is at least 10% post-consumer waste, chlorine free, and is Forest Stewardship Council ® (FSC ®) certified. FSC ® is not responsible for any calculations on saving resources by choosing this paper.
Now, let’s take a journey through our incredible Southwest Conservation Hub, in this issue of the Journal
Paul A. Baribault President and Chief Executive Officer

2 / SAN DIEGO ZOO WILDLIFE ALLIANCE JOURNAL / SEPTEMBER/OCTOBER 2023
LETTER FROM THE PRESIDENT AND CHIEF EXECUTIVE OFFICER
JOURNAL
PHOTO
BY: TAMMY SPRATT/SDZWA
Onward,
Close to Home
Characterized by year-round warm temperatures, low annual precipitation, and clear skies, the Southwest encompasses diverse ecosystems and equally distinctive wildlife. Including much of the Mojave, Sonoran, and Chihuahua deserts (as well as some of the surrounding areas), the Southwest is a fascinating conservation hub—and it starts right here in our own backyard.
2
The Torrey pine grows naturally in only two places— along a few miles of the San Diego coast and on Santa Rosa Island.

The number of desert tortoises that might share a single underground burrow. 25

93
California’s mountain yellowlegged frog has disappeared from more than 93 percent of the species’ native range.

After two decades of being considered extinct, a tiny remnant population of Pacific pocket mice was rediscovered in 1993 at Dana Point Headlands in Southern California. 180

Ringtails are able to rotate their hind feet 180 degrees, which allows their footpads to stay in contact with the surface as they descend vertically from trees.

2023 Board of Trustees
OFFICERS
Javade Chaudhri, Chair
Steven G. Tappan, Vice Chair
Gary E. Knell, Vice Chair
Steven S. Simpson, Treasurer
Richard B. Gulley, Secretary
TRUSTEES
Rolf Benirschke
Kathleen Cain Carrithers
E. Jane Finley
Clifford W. Hague
Linda J. Lowenstine, DVM, Ph.D.
Bryan B. Min
TRUSTEES EMERITI
Berit N. Durler
Thompson Fetter
Robert B. Horsman
John M. Thornton
Executive Team
Paul A. Baribault
President and Chief Executive Officer
Shawn Dixon
Chief Operating Officer
David Franco
Chief Financial Officer
Erika Kohler
Executive Director, San Diego Zoo
Lisa Peterson
Executive Director, San Diego Zoo Safari Park
Nadine Lamberski, DVM, DACZM, DECZM (ZHM)
Chief Conservation and Wildlife Health Officer
Wendy Bulger
General Counsel
David Gillig
Chief Philanthropy Officer
Aida Rosa
Chief Human Resources Officer
David Miller
Chief Marketing Officer
SAN DIEGO ZOO WILDLIFE ALLIANCE / SDZWA.ORG / 3
BY THE NUMBERS
PHOTOS BY: (TOP, MIDDLE, BOTTOM LEFT) KEN BOHN/SDZWA, (BOTTOM RIGHT) IMAGEBROKER / ALAMY STOCK PHOTO
UP TO
1993
San


Landmark Javan Leopard Survey





With only 29 suitable—but very small— landscapes remaining for Javan leopards in Indonesia, it is critical that we understand where—exactly—these endangered cats live and how many are left. Our team and partners in Indonesia recently completed a trail camera survey in the Belambangan Biosphere Reserve, one of the last areas where Javan leopards are found; and this is the first-ever systematic trail camera survey of leopards in the reserve. We hope to use these data to estimate the density of leopards in this landscape, and we will share our findings with national biodiversity reserve managers to help guide protections for leopards and the key landscapes they inhabit.
Big Help for a Tiny Plant
SDZWA’s Native Plant Gene Bank team joined our partners on an expedition into the AnzaBorrego desert to locate a very rare, tiny species, Linanthus maculatus emaculatus (pictured next to a dime, for size reference). The species is known from just a few locations, but the expedition group was able to locate and map a new population, and make a conservation seed collection. A portion of the seed will be available for research into the germination and propagation requirements of the species, while most of the collection will go into long-term storage, ensuring that seeds can be revived and grown into plants for restoration purposes in the future.

Collaborating to Protect the Platypus



As platypuses are increasingly threatened by more frequent and severe bushfires and droughts, SDZWA is committing to a renewed and expanded collaboration for platypus conservation. We will be partnering on a platypus emergency response and resilience initiative led by the Taronga Conservation Society Australia. The initiative includes building capacity for platypus recovery, and providing temporary refuge to wild platypuses in need of care or protection due to injury or environmental factors that contribute to successful conservation interventions, including translocations. Our collaboration will also work toward establishing an ex situ assurance population that will serve as a source for future platypus translocations.
Gorilla Nesting Behavior

Our team and collaborators in Cameroon recently completed a five-year study of gorilla nesting behaviors in the Ebo forest. The team found that Ebo gorillas prefer to nest within high-altitude sites in open canopy forest with dense undergrowth, and that overall, the gorillas used more than 281 plant species to construct their nests. These findings illustrate the importance of conserving this highly biodiverse forest habitat. The Ebo gorilla population was first documented by SDZWA scientists in 2002, and we believe there are fewer than 25 gorillas remaining in this area today. We continue to work alongside local communities to protect these rare primates and their unique habitat.

4 / SAN DIEGO ZOO WILDLIFE ALLIANCE JOURNAL / SEPTEMBER/OCTOBER 2023
FINDINGS
Diego Zoo Wildlife Alliance (SDZWA) protects and restores nature in eight conservation hubs on six continents. Below are recent discoveries and progress reports from around the world.
PHOTOS: (TOP LEFT) SDZWA, (TOP RIGHT) KEN BOHN/SDZWA, (BOTTOM RIGHT) SDZWA, (BOTTOM LEFT) SDZWA/BKSDA EAST JAVA/SINTAS
JUNE 2024
Botswana
Explorer Safari
Come explore where wildlife reigns.
Travel with us and experience the WONDER OF WILDLIFE.
Small Groups•Dedicated Hosts•Amazing Wildlife•Awe-inspiring Locations

SEPTEMBER 2024
Madagascar Wildife Adventure

Explore rare habitats, national parks, and private reserves.
For details about these trips and all our Adventures, visit: adventures.sdzwa.org
Photos by: Natural Habitat Adventures, SDZWA
Q Q
What drew you to the field of zoo architecture?
I didn’t become an architect because I wanted to design buildings. I wanted to design "built experiences" that connect people to nature—to share the sense of wonder and awe that I experience personally in natural environments. As an undergraduate, I attended a lecture by environmental psychologist Judith Heerwagon on biophilic design principles [connecting people to nature through design] in architecture. Then, I read Biophilia by Edward O. Wilson—about how we are evolutionarily hardwired to seek out and respond to specific elements in the natural world. That led me to do an independent course of study on the topic of biophilic design theory in architecture in my senior year.
Reaching a large number of people was, and still is, important to me, because awe, joy, wonder, and love of nature are at the heart of conservation. The more of us there are that feel this way, the more successful our conservation efforts will be—now and in the future. Zoo design seemed like the best opportunity to create these types of experiences for as many people as possible.
What kind of educational background prepared you for such a specialized career?
I did concurrent master's programs in architecture and landscape architecture, and throughout the course of my studies, I viewed everything through the lens of connecting to nature. My landscape architecture master’s research thesis was “Designing for Ecoliteracy in Twenty-first Century Zoological Parks.” This allowed me to do a year-long deep dive into the
Vanessa Nevers
What is “ecoliteracy,” and why is it important?

Broadly speaking, it’s the ability to understand the principles of natural systems that are essential for life—and to actualize this understanding in the advancement of ecologically sustainable human communities.
Q 6 / SAN DIEGO ZOO WILDLIFE ALLIANCE JOURNAL / SEPTEMBER/OCTOBER 2023
topic of zoological design and its relationship to supporting conservation through the idea of fostering ecoliteracy in zoo visitors. It supports and informs the work I do today.
What do you see as the future of zoological park design?

As we move forward with increasing awareness of the interconnectivity of all life, the importance of biodiversity, and holistically sustainable ways of living, I see zoo design responding by moving toward more complete ecosystem experiences, for both wildlife and guests, that emphasize the criticality and beauty of these interrelated systems.
What has surprised you about working in zoo architecture?
The most surprising is the sheer magnitude of variables that need to be considered when designing and building habitats for wildlife. I’m still surprised, on an almost daily basis, by the amazing ingenuity and resourcefulness of animals. Fortunately, SDZWA has an outstanding, knowledgeable team of curators and wildlife care specialists to help work out all the important variables that need to be addressed in habitat design.
What is the coolest thing about your job?
Two things stand out to me as the most rewarding: seeing wildlife enjoying their new habitats, and the guests’ expressions of excitement and joy as they explore new experiences.
What inspires you?
Nature—and all of the beautiful manifestations of life that comprise it!
Q Q Q Q PHOTO BY: KEN BOHN/SDZWA
MEET OUR TEAM
An SDZWA architect, Vanessa collaborates with team members to plan and design new habitats and renovation projects, taking them from ideas to the final experiences you see at the Zoo.


Shell Game
Kim Gray, curator of herpetology and ichthyology for SDZWA, outlines the effects the illegal wildlife trade has on turtle and tortoise species.
This spring, we celebrated the oneyear anniversary of our Wildlife Explorers Basecamp—and for those of us involved in this amazing project, it has been an incredible first year.
Spotted turtles and wood turtles are two species that call the Marsh Meadows

habitat at Wildlife Explorers Basecamp home. The group of spotted turtles have settled into their home very well; they are growing and have already welcomed three offspring. These species are some of our guests’ favorites, as they are usually seen swimming and interacting with other turtles in the habitat or basking on logs,
in the sunshine. Unfortunately for some wildlife, their appeal can threaten their population sustainability. Many people don’t realize that illegal trade in wildlife is significantly impacting these species.
The number of confiscated North American turtle species increases every year as the demand for them in foreign
8 / SAN DIEGO ZOO WILDLIFE ALLIANCE JOURNAL / SEPTEMBER/OCTOBER 2023
HOT TOPICS
Improving the Odds for Turtle and Tortoise Population Sustainability
this number represents only the ones that were caught. These numbers also do not reflect those turtles exported legally; and in 2018, 1.41 million turtles were sent overseas, mainly to markets in Asia and Europe for the pet trade and food markets. These numbers highlight the demand for turtles, but given the basic biology of many of these species, these numbers are simply not sustainable.
Many of the turtles targeted only lay four to five eggs once per year, and if conditions are not right—such as during drought or when their habitats are poor— they may not nest at all. Turtles and tortoises are also slow to mature, meaning it may take many years before the young turtles are able to reproduce—and young turtles are more susceptible to predators, so many do not make it to maturity.
and tortoises in the Philippines and Madagascar.
Our hope is that through the work of our Alliance partners, more support for stronger regulations at the state level and wildlife law enforcement, paired with demand reduction education and outreach, will help reduce the number of turtles entering the illegal trade. Long-term goals, including understanding genetics and disease risks of the confiscated turtles, can help us create best practices for returning them to native habitats, where they can contribute to healthy turtle populations and healthy environments.
markets likewise increases. From 2018 through 2021, nearly 20,000 turtles— including box turtles, wood turtles, musk turtles, spotted turtles, and diamondback terrapins—were confiscated on their way out of the US. Unfortunately,

North America is a biodiversity hotspot for turtles—57 species of turtles are found in the US and Canada, with the US having more species than any other country in the world. Almost 40 percent of our native turtles are threatened with extinction. SDZWA is a Platinum member of the Wildlife Trafficking Alliance, and we partner with various other government agencies to help combat this illicit trade. One of the ways we help is by providing homes for animals directly impacted by wildlife trafficking. The spotted turtles and wood turtles in our Marsh Meadows habitat at Wildlife Explorers Basecamp were rescued from trafficking. We have sent our wildlife care and veterinary staff overseas during other large-scale confiscations, to help provide care to impacted turtles

SAN DIEGO ZOO WILDLIFE ALLIANCE / SDZWA.ORG / 9
PHOTOS BY: KEN BOHN/SDZWA
North America is a biodiversity hotspot for turtles—57 species of turtles are found in the US and Canada.
The Multi-layered Plan to Save the Mountain Yellow-legged Frog
 BY DEBRA SHIER, PH.D., TALISIN HAMMOND, PH.D., SPENCER SIDDONS, PH.D, RON SWAISGOOD, PH.D., AND CANDACE WILLIAMS, PH.D.
BY DEBRA SHIER, PH.D., TALISIN HAMMOND, PH.D., SPENCER SIDDONS, PH.D, RON SWAISGOOD, PH.D., AND CANDACE WILLIAMS, PH.D.
It was an amphibian mystery: in the 1970s, frogs around the world began inexplicably dying. Sometimes the declines were slow and steady. In other cases, sudden and massive die-offs were documented—even in protected and pristine areas. It wasn’t until scientists from around the world gathered at the first World Congress of Herpetology in 1988 and shared similar observations that they realized something bigger was happening. But there was no clear explanation for why so many frogs were vanishing.
Global Diagnosis, Local Treatment
In 1998, a fungal pathogen—amphibian chytrid fungus Batrachochytrium dendrobatidis—was discovered. It infects frogs’ skin, disrupting their ability to breathe through their skin and their osmoregulation (a process to maintain the osmotic pressure of fluids and electrolytic balance in their systems). Unfortunately, these disruptions have potentially fatal conse-
quences. In combination with other threats like habitat loss, pollution, introduced predators, and climate change, this chytrid pandemic—largely spread by human movement of frogs in the food and pet trades—continues to contribute to losses of amphibians around the world, as well as here at home.
More Than Skin Deep 2 100 11K
One representative of this global crisis can be found nearby. The southern mountain yellow-legged frog Rana muscosa was, until recently, the most abundant amphibian in Southern California’s mountain lakes and streams. Their abundance made them a keystone predator and prey, as well as a critical agent of nutrient and energy cycling in the mountain aquatic ecosystem. The species faces many of the same threats causing amphibian declines globally—including chytrid. Currently, only a few hundred wild adults remain at only eight locations in the endangered southern segment. This is a population decline of more than 98 percent; and sadly, these frogs no longer remain in San Diego County.
10 / SAN DIEGO ZOO WILDLIFE ALLIANCE JOURNAL / SEPTEMBER/OCTOBER 2023
There are two species of mountain yellow-legged frogs: the southern mountain yellow-legged frog, and the Sierra Nevada mountain yellow-legged frog.
In less than 100 years, the southern mountain yellowlegged frog has been driven to the brink of extinction.
The number of mountain yellow-legged frogs that have been translocated back into their native ranges in Southern California.
PHOTO BY: KEN BOHN/SDZWA

Jumping into Action
In 2006, San Diego Zoo Wildlife Alliance (SDZWA) got involved. The U.S. Fish and Wildlife Service asked our organization to participate in an emergency rescue operation. Tadpoles from a drying pool were collected and transported to SDZWA facilities, to develop care and breeding protocols. The hope was that these protocols could be used to prevent the complete loss of a last remaining, unique lineage of this species— an opportunity to save biodiversity right in our own backyard.
Since that time, our frog program has
transformed into a full-scale conservation breeding and reintroduction operation, using genetic data to inform management. While tadpoles have a very low rate of survival in their native habitats, our ex situ facility can support them through metamorphosis into larger, hardier froglets. Since our first reintroduction in 2010, our interagency group has translocated more than 11,000 mountain yellow-legged frogs back into their native ranges.
Many threats have been addressed, and we have made a great deal of progress with our program. For example, trout and bull-
DID YOU KNOW?
Mountain yellow-legged frogs have a slow pace of life, and in their native habitat can sometimes remain as tadpoles for two full years or more!
frogs are voracious predators of these frogs and their offspring, and our partners have worked to remove and exclude these non-native species, allowing frog populations to persist—and even grow, in some locations. In collaboration with our reproductive science, wildlife nutrition, and conservation genetics teams, our research has helped us determine everything from the best diet to the importance of mate choice and brumation (hibernation in ectothermic, or cold-blooded animals) for reproductive fitness, to genetically informed management recommendations. We’ve monitored hormones, studied sperm,

12 / SAN DIEGO ZOO WILDLIFE ALLIANCE JOURNAL / SEPTEMBER/OCTOBER 2023
PHOTO BY: KEN BOHN/SDZWA
developed methods for assisted reproduction, and cryopreserved gametes and cell lines. We have also established pre-release environ mental conditioning procedures, teaching frogs to recognize and re spond to predators, and to swim and jump in running water before reintroduction. Today, we can raise large numbers of frogs in human care that are well-prepared to survive in their native habitats. This work has slowed the path to extinction, but the problem of ch ytrid persists, and we must surmount this obstacle to successfully recover the species.
Measuring the Outcome
To evaluate the success of our efforts, our team conducts post-release monitoring, including disease surveillance. When we find frogs in native habitats, we collect a non-invasive skin swab (which looks a lot like the COVID-19 swabs that we’re now so familiar with), and we work with our Disease Investigations team to test for the presence of chytrid DNA. If we find frogs that have perished in native habitats, we bring them to our expert pathol ogists to conduct necropsies. Through these efforts, we have documented fatalities associated with chytrid at multiple reintroduction sites—a dev astating finding for our devoted team, who cared for and raised these frogs to return to native habitats.
Getting rid of the fungus in native habitats is likely unfeasible. It is present at all mountain yellow-legged frog sites in Southern Cal ifornia, and is often found on the skin of co-occurring amphibian

species. Chytrid is even found in the water and soil. So the question isn’t how we can prevent exposure of frogs to chytrid; but rather, how can we help the frogs persist in their native habitats with chytrid?
We’re starting by working toward a better understanding of the fungus itself. Last fall, our team sampled chytrid from frogs living in native habitats, and was able to successfully culture, isolate, and cryopreserve chytrid samples from multiple locations. We are working with geneticists at the University of California, Berkeley to characterize differences in chytrid across mountain yellow-legged frog sites. In coming years, we may also implement a method used in other species threatened by chytrid, which involves infecting frogs and clearing their infections before release. This strategy is thought to prepare the immune system for future exposure to the disease, similar to how a vaccination works. These experiments will also shed light on whether some populations or individuals are less susceptible to chytrid, which could point toward potential

Amphibians’ skin is their first line of defense against pathogens like chytrid, and their skin microbiome is one critical component of this protection. Beneficial microbes can make some amphibian species—including the mountain yellow-legged frog—less susceptible to chytrid. We are currently reviving cryopreserved chytrid samples to develop an anti-chytrid “probiotic,” a

SDZWA.ORG / 13
PHOTOS BY: (TOP) KEN BOHN/SDZWA, (CENTER) SDZWA
Hop to it:
(Above from left): Researchers from San Diego Zoo Wildlife Alliance unpack frogs from temperature-controlled containers to prepare them for reintroduction into their native habitat; a skin swab is carefully and gently collected to test this mountain yellow-legged frog for the amphibian chytrid fungus.
skin microbial augmentation treatment for this species. Additionally, we have collected thousands of skin swabs from mountain yellow-legged frogs to characterize how the skin microbiome varies in frogs of different ages and in different settings (in situ vs. ex situ), and perhaps most critically, in frogs with and without chytrid infections in native habitats. Ultimately, our hope is to protect frogs from chytrid in the short-term, in order to buy them enough time to evolve resistance.
The task ahead is daunting, but the case of yellow-legged frogs in the Sierra Nevada mountains is a story of hope and a blueprint for conservation success that we can use. These close relatives of mountain yellow-legged frogs in Southern California are showing signs of recovery after experiencing severe chytrid-related declines. Translocations using frogs that are thought to have evolved lower susceptibility to chytrid was a key part of the recipe for recovery in the Sierra Nevada mountains.
A Leap of Faith for the Future
Some may ask why we work so hard to save a frog. Apart from their important and unique
role in Southern California’s at-risk aquatic ecosystems, mountain yellow-legged frogs have been California residents for a long time: at least 8 to 12 million years—roughly 30 to 50 times longer than Homo sapiens have been on the planet! Hikers and campers used to enjoy the frogs’ presence in the mountains of Southern California, and would be posting their images on social media if they were there to photograph today. In less than 100 years—an evolutionary blink of the eye— this species has been driven to the brink of extinction due to human activity.
At the same time, disease-related declines in wildlife populations and zoonotic diseases (diseases transmitted between wildlife and people) are both on the rise. By mitigating threats such as the amphibian chytrid fungus, we hope to work toward saving amphibians like the mountain yellow-legged frog, and someday, they may even be San Diego residents again.

Many children go through a “frog phase,” when they become fascinated by these amazing amphibians. We believe everyone should have a lifelong frog phase,
caring enough to conserve them and —hopefully—one day seeing this species thrive in its native habitats once more.
Debra Shier, Ph.D., is the Brown Endowed Associate Director of Recovery Ecology for SDZWA; Talisin Hammond, Ph.D., is an SDZWA scientist; Spencer Siddons, Ph.D., is an SDZWA postdoctoral associate; Ron Swaisgood, Ph.D., is SDZWA’s Brown Endowed Director of Recovery Ecology; Candace Williams, Ph.D., is an SDZWA researcher.
A frog first: Mountain yellow-legged frogs historically inhabited montane streams and lakes (like above), but in Southern California they are currently limited to stream sites—until this year! In 2023, SDZWA, in partnership with the U.S. Fish and Wildlife Service, the California Department of Fish and Wildlife, The Wildlands Conservancy, the U.S. Geological Survey, and other partners; reintroduced frogs to a lake site, a first for the Southern California populations!

14 / SAN DIEGO ZOO WILDLIFE ALLIANCE JOURNAL / SEPTEMBER/OCTOBER 2023
PHOTOS: KEN BOHN/SDZWA


© 2023 The Coca-Cola Company.
BOTTLES RECYCLED HERE CAN BECOME A NEW BOTTLE. “100% Recycled Bottle” refers to bottle, not cap and label.
NEW LOOK. SAME PLASTIC.
Growing Together
The Native Biodiversity Corps
BY LINDSEY KORITO, MAGGIE REINBOLD, AND MADELINE SANCHEZ
Driving conservation action through science education and community collaborations is the tagline we often use to describe the work of SDZWA’s Community Engagement team. From working alongside teachers to
incorporate conservation science content into classrooms, to co-generating and co-testing solutions, in support of human-wildlife coexistence, our work focuses on the people side of each conservation equation. One program that most perfectly embodies this pithy tagline is also our
newest: the Native Biodiversity Corps.
At the Core of the Corps
The Native Biodversity Corps brings together inner-city high school students from diverse cultural, ethnic, and livedexperience perspectives for immersive


16 / SAN DIEGO ZOO WILDLIFE ALLIANCE JOURNAL / SEPTEMBER/OCTOBER 2023
social learning experiences designed to enhance their inquiry and critical thinking skills. During this multi-month training program, Corps members work alongside SDZWA team mentors and other experts to design, implement, maintain, and monitor native wildlife gardens on their school campuses. These gardens represent resilient living “laboratories” that not only attract and support local wildlife, but also promote regional pride, and provide places for renewal, discovery, and cross-curricular learning for students, teachers, and community members.
The main goal of the program is to provide Corps members with opportunities to discover and learn about native wildlife species, increase their interest in careers related to species recovery and restoration, and enhance their appreciation of their unique natural heritage and how people impact the health and composition
of our local ecosystems. To achieve this, Corps members spend 10 to 20 hours per month on their school campuses surveying for appropriate sites, developing specific garden plans, putting approved garden designs into action, debuting new wildlife gardens for faculty and classmates, and co-developing plans for shortterm and long-term garden maintenance and sustainability.
The students also participate in several nature-based learning experiences at local wildlife conservation sites. During these visits, they build knowledge and passion for native plants and animals of the region, explore the intricacies of ecosystem dynamics, and examine the many physical, ecological, and anthropogenic elements of effective native landscape design. These visits also allow students to critically evaluate how human-driven change in our environment relates

to changes in fire regimes, water usage, and ultimately loss of local biodiversity in Southern California and beyond. This kind of immersive, nature-based learning is especially important now, as species are declining at unprecedented rates right here in San Diego, which is part of the California Floristic Province, a world-renowned biodiversity hotspot.
When the program debuted in Spring 2022, thanks to funding from the Level Up Program, more than 300 urban high school students registered in less than 72 hours, validating the need for this kind of hands-on, skill-building mentorship program. Roughly 100 students were accepted into the program and spent a portion of their summer exploring local conservation sites—including the San Diego Zoo and Safari Park, San Diego Natural History Museum, Living Coast Discovery Center, and San Elijo Lagoon
SAN DIEGO ZOO WILDLIFE ALLIANCE / SDZWA.ORG / 17
PHOTOS BY: SDZWA
—Mariana J., 10th grade, Hoover High School
The program taught me the importance of collaboration, leadership, and teamwork, and showed me how small actions can make a positive impact on the environment.



18 / SAN DIEGO ZOO WILDLIFE ALLIANCE JOURNAL / SEPTEMBER/OCTOBER 2023
—Lucas H., 12th grade, Crawford High School
This program has shown me how much I love biodiversity! It has inspired me to get a business or biology degree in order to keep helping our environment.
Ecological Reserve—before applying their new skills and knowledge to the design and construction of native wildlife gardens on the campuses of Crawford, Hoover, and Lincoln high schools.



This incredible new program has helped us build connections with key community partners across our region. While Corps members primarily work alongside SDZWA Conservation Science and Wildlife Health team members, they also engage with local experts from a variety of backgrounds and institutions including the Escondido Creek Conservancy, San Diego Master Gardener Association, San Diego Botanic Garden, and City Farmers Nursery.
—Jay L., 10th grade, Hoover High School
Nurturing Connections
The Corps program has also helped us deepen our connection with another critically important local partner: San Diego Unified School District (SDUSD). SDUSD is one of the largest school districts in the nation, supporting more than 100,000 students on more than 200 K-12 campuses. We have thoroughly enjoyed working alongside SDUSD students, teachers, staff, and administration to make the program as engaging and effective as possible, and to promote the incorporation of native landscape design practices on a wider scale. For example, when the program began last year, there were only four native plant species approved for use on SDUSD campuses. Through thoughtful collaboration among students, teachers, staff (both SDZWA and SDUSD), and administration, there are now nearly 30 native plant species approved for use on SDUSD campuses.
The program has also helped foster key relationships within each campus community. Corps members have worked closely with the garden clubs on each campus to enhance pre-existing natural spaces by incorporating native species whenever possible, including into food crop gardens. Corps members have also enjoyed myriad opportunities to demonstrate their leadership skills as they guide classmates through the garden implementation and maintenance process, and also share the results of their work with SDZWA researchers and scientists during an annual Student Summit at the Beckman Center for Conservation Research.
Incorporating robust native gardens on multiple campuses across San Diego helps create vital habitat corridors, providing pollinators and other wildlife with access to critical resources in highly urbanized areas. The program gives Corps members an opportunity to plant the seeds for future students to nurture on their school campuses while also building knowledge and appreciation for the many threatened and endangered native species that share our region. This exciting new program demonstrates the exceptional capacity of local students to drive conservation action for the biodiversity in our own backyard. With more than 40 school districts and nearly half a million students across San Diego County, this budding program has endless growth potential.
Maggie Reinbold is director of community engagement for SDZWA; Lindsey Korito is a research associate for SDZWA; Madeline Sanchez is a research associate for SDZWA.
SAN DIEGO ZOO WILDLIFE ALLIANCE / SDZWA.ORG / 19 PHOTOS BY: SDZWA ARTWORK COURTESY OF HOOVER HIGH SCHOOL’S 2022 NATIVE BIODIVERSITY CORPS TEAM
My motivation is my desire to assist in beautifying Hoover’s campus, in turn helping the reputation of both the program and the school.
Cell therapy:
To treat an arthritic California condor, arthesenchymal stem cells were administered both locally in the area of the affected joint and intravenously. A computed tomography (CT) scan was used to not only guide adipose tissue collection but also to localize the joint space for mesenchymal stem cell injection.

Generating Hope
Regenerative Medicine in Veterinary Care
BY MATTHEW E. KINNEY, DVM, DACZM | PHOTOS BY KEN BOHN
Regenerative medicine is a relatively new approach to patient care that is focused on the repair, replacement, or regeneration of cells, tissues, or organs to restore impaired function, from a variety of causes. The veterinary staff at San Diego Zoo Wildlife Alliance (SDZWA) uses regenerative medicine techniques in a variety of clinical cases, with a focus on one particular area of regenerative medicine: mesenchymal stem cells.
Going Cellular
Mesenchymal stem cells have the capacity for self-renewal, and can differentiate into a number of different cells. These types of stem cells can be collected from fat and umbilical cord tissue, shortly after the birth of an animal.
SDZWA’s wildlife health teams have not only embraced regenerative medicine, but have become leaders in the use of this non-traditional modality. Over two decades ago, mesenchymal stem cells were first used at the San Diego Zoo Safari Park following fat collection, cell isolation, and re-administration into a zebra that was diagnosed with orthopedic disease, causing hind limb limping.
The improvements observed in that case resulted in veterinarians further exploring the treatment possibilities offered, by translating techniques and indications for use from domestic animal veterinary medicine and human medicine. Since initial use over two decades ago, SDZWA wildlife health teams have been both preparing for potential cases and utilizing mesenchymal stem cells in a variety of clinical cases.
20 / SAN DIEGO ZOO WILDLIFE ALLIANCE JOURNAL / SEPTEMBER/OCTOBER 2023
SDZWA’s


An Early Start
The plan to use mesenchymal stem cells is often initiated well in advance of their intended use—in some instances, even before the patient is born! Cells contained within the umbilical cord have a high percentage of mesenchymal stem cells, and therefore this tissue is a great source to collect from for further storage and clinical use. In many instances, wildlife health and care teams will work together closely after an animal is determined to be pregnant, to plan for the collection of the umbilical cord—which is naturally separated from the offspring shortly after birth. The actual collection and processing of the cord can be a challenge, as the tissue must be collected safely and without disrupting the bond between the offspring and mother. Once collected, the cord is cleaned, and specific sections are taken for cell harvesting at a laboratory in the San Diego area.
After a few weeks, the cells are cultured, expanded, and frozen for clinical use. These cells can be stored for years until a clinical use arises, at which time they are unfrozen and can be administered to a patient within a day or two, which is often faster than some medicines can be ordered and delivered. Mesenchymal stem cells are not specific to individuals, so one individual within a species may be the “donor,” but their cells can be administered to herd or flock mates, if needed.
Good Fat
In addition to obtaining cells from umbilical tissue, another common source is adipose tissue, or fat. Adipose tissue collection for cell harvesting does not require the birth of an offspring, and it can be collected from an animal of any age. Cheetah cells proved to be among the more difficult to collect, as cheetahs have minimal subcutaneous (underneath-the-skin) fat. However, a large amount of fat can be collected from the abdominal cavity, and this was obtained opportunistically in a cheetah at the San Diego Zoo Safari

SAN DIEGO ZOO WILDLIFE ALLIANCE / SDZWA.ORG / 21
DID YOU KNOW?
wildlife health teams have become leaders in the use of regenerative medicine.
Park during a laparoscopic surgical procedure. In most other mammal species, fat can be found immediately beneath the skin, allowing easy sampling. In birds, fat can be a little more difficult to obtain, as the location of fat stores can vary greatly between species. The wildlife health team recently performed a computed tomography (CT) scan on a California condor, as part of a diagnostic evaluation, and to locate an area of abundant and accessible fat stores to collect for mesenchymal stem cell culture.

Just the Beginning

Once umbilical or adipose tissue is collected and mesenchymal stem cells are isolated, they can be used for clinical cases with very little advance notice. By far the most common use of regenerative therapy is for diseases affecting bones and cartilage that surround joints. In addition to regenerative capacity, cell-related factors likely influence the microenvironment of the diseased tissue, which may have direct anti-inflammatory and pain-relieving effects.

Mesenchymal stem cells have been used in a traditional application for degenerative joint disease on a variety of species at the San Diego Zoo and Safari Park, including giraffes, rhinos, and California condors. This modality has also been applied as a novel therapy for treatment of non-orthopedic-related disease in a variety of animals. Repeated intravenous administration of mesenchymal stem cells has been used in cheetahs with severe liver disease, and in African elephants with viral infections. The use of regenerative medicine in zoological veterinary practice remains in its infancy. Thoughtful planning to maximize collection opportunities, identification of disease processes that may benefit from cell or tissue repair and regeneration using these cell types, and preparing cells well in advance of their anticipated use has allowed us to apply these modalities for timely and effective treatment in a variety of patients.
EVERY FRIDAY, SATURDAY & SUNDAY IN OCTOBER!
Our popular October event is back, and bigger than ever! Join us on Fridays, Saturdays, and Sundays in October to help us light up the night until 9 p.m.! Youths 11 and younger are free, and may come in costume.
There is fun for the whole family, with musical entertainment, dance parties, special performances, and more—plus Dr. Zoolittle, Zoo characters, and tempting food specials.
sandiegozoo.org
Matthew E. Kinney, DVM, DACZM, is a senior veterinarian for SDZWA.
YOU’RE ON WITH AMAZING WILDLIFE
Meet Our Hosts
As San Diego Zoo Wildlife Alliance’s Amazing Wildlife roars into a second season of unique insights into the intricacies of wildlife conservation, we thought it was time to get to know a unique species—our podcast hosts! Find out what inspires wildlife ambassadors Rick Schwartz and Marco Wendt to help lead the way toward a world where all life thrives. Amazing Wildlife is available on the iHeart app, Apple podcasts, or wherever you listen to your favorite podcasts.

Q. How did you get started with SDZWA?
RICK: In 2000, I started as a part-time wildlife care specialist in the Children’s Zoo (now Wildlife Explorers Basecamp) at the Zoo.

MARCO: I started at 16, as a wildlife care specialist at the Safari Park’s Lorikeet Landing habitat, and also at the iconic Frequent Flyers bird experience.

Q. What has been your favorite topic or guest?
RICK: It’s fair to say all of our guests are great and I always learn something from them, but I’d have to say it was a special experience to have Dr. Jane Goodall on the podcast.
MARCO: My absolute favorite episode so far has been our Nocturnal Wildlife episode. It stands out to me, because that was the first time Rick and I recorded on location at the Zoo, and we got to showcase wildlife that often are misunderstood and get a bad rap.
Q. Are you getting feedback from your audience?
RICK: Yes, and it’s great to hear from our listeners. At in-person talks that we give, we can see and hear the audience. But with podcasting, we
are just talking to each other. So, it’s great when we get listener feedback on social media or during in-person meetings.
MARCO: Yes! I am now getting people recognizing me simply by my voice— that has never happened to me before! Listeners are loving how adults and children can both be entertained and, at the same time, learn something wild about nature.
Q. Is there an episode that you think is the best?
RICK: Well, I think it might be hard to pick a best, but I will say I had a lot of fun with Marco recording the Pacific Pocket Mouse episode—oh, and the Nighttime Zoo/Nocturnal Animal episode that he mentioned.
MARCO: I think the best episode so far has been “The Little Mouse that Matters: Pacific Pocket Mouse.” It highlights the diversity of wildlife. When we think of wildlife conservation, most immediately think of megafauna like elephants, giraffes, or rhinos. But all creatures, great and small, need our support and understanding.
Q. Finally, if you could be any animal, what would it be?
RICK: A binturong, of course! Living life in the trees of the rainforest,
eating fruit, and taking naps—all while smelling like buttered popcorn—who wouldn’t want to be a binturong?
MARCO: A crested caracara, hands down! A falcon that acts like a vulture— what’s not to love?!
SAN DIEGO ZOO WILDLIFE ALLIANCE / SDZWA.ORG / 23
RickSchwartz
MarcoWendt
Flight School
The Science Behind Butterfly Migration

Butterfly migration is a fascinating natural phenomenon where some species travel thousands of miles to escape harsh weather conditions or in response to limited resources. These winged wonders fly to areas with abundant food sources, such as nectar-rich flowers, to ensure better nourishment for themselves and their larvae, and to find a suitable place to breed. Here’s a look at a few of those frequent flyers.
M onarch
Danaus plexippus
Monarch butterflies can travel up to 100 miles a day; and some fly as far as 3,000 miles to spend the winter. In North America, the eastern monarch population heads to Mexico’s

Sierra Madre mountains
Western monarchs overwinter along the California coast .
Question Mark
Polygonia interrogationis
Question mark butterflies are found from southern Canada, throughout the east, down to Florida and the Gulf of Mexico; and west to Arizona and Colorado. Some of them migrate individually—rather than en masse— from their northern homes to warmer southern US states and are often found along the Gulf Coast, while others overwinter.
Cloudless Sulphur
Phoebis sennae
Each fall, the cloudless sulphur’s migration pattern starts at its breeding sites in the northern United States and heads to Florida and other parts of the southern US. This is home until the end of winter, then it’s back north to the same breeding sites.
24 VISUALIZE IT
Illustration by Amy Blandford
Red Admiral
Vanessa atalanta
The red admiral is one of the most common butterfly species in the world. Its range includes North Africa, Asia, Europe, North and Central America, the Caribbean, and the Hawaiian Islands. Red admirals in North America migrate from as far north as Canada to spend the winter in southern Texas.

Common Buckeye
Junonia coenia
Found across the southern US and much of Mexico, the common buckeye annually increases its range northward to temporarily colonize much of the US and, occasionally, southern Canada
In late summer and continuing through fall, masses of adults move southward into peninsular Florida, where the adults overwinter.
Painted Lady
Vanessa cardui
Painted lady butterflies are found all over the world and have many migration routes that are not necessarily dictated by seasonality. During the US migration in spring, they head northwest from their winter homes in Southern California deserts, sometimes in very large numbers (the trip may take several generations to complete).
25
September and October Hours
San Diego Zoo*
September 9 a.m.–6 p.m.
October
Monday–Thursday 9 a.m.–6 p.m.
HalGLOWeen
Friday–Sunday in October 9 a.m.–9 p.m.
San Diego Zoo Safari Park*
September 9 a.m.–5 p.m.
October
Monday–Friday 9 a.m.–6 p.m.
Autumn Festival
Saturday–Sunday in October 9 a.m.–7 p.m. sdzwa.org
SAN DIEGO ZOO
FRIDAYS, SATURDAYS, AND SUNDAYS IN OCTOBER HalGLOWeen
The Zoo’s Halloween themed celebration offers family fun, music, and live entertainment from 5 to 9 p.m. every Friday, Saturday, and Sunday in October.

On October 1, SDZWA members are invited to enjoy a HalGLOWeen Member Preview. (Z)
SEPTEMBER 23
Food, Wine & Brew Celebration
This annual fundraiser for San Diego Zoo Wildlife Alliance features tastes of gourmet cuisine, wines, and beers from San Diego’s finest eateries, brewers, and vintners. (Z)
OCTOBER 1–31
Kids Free
619-231-1515
*Exceptions apply. Programs and dates are subject to change—please check our website daily for the latest information and requirements for visiting.
(Z) = San Diego Zoo
(P) = Safari Park
Throughout the entire month of October, youths ages 11 and younger receive free admission to the San Diego Zoo. (Z)
SEPTEMBER 10 AND 15;
OCTOBER 20
Plant Day and Orchid Odyssey
On these special days, guests can take a rare look inside the Zoo’s Orchid Greenhouse from 10 a.m. to 2 p.m., learn about the Zoo’s botanical collection from Horticulture staff on the Botanical Bus Tour at 11 a.m., and check out the Carnivorous Plant Greenhouse from 11 a.m. to 1 p.m.
Each month on Plant Days, a variety of plants will be available for purchase—all grown on site by Zoo horticulture staff. The Plant Sale takes place from 10 a.m. to 2 p.m. in front of the Orchid Greenhouse entrance. The September 10 date includes Carnivorous Plants and Orchid Greenhouse only. (Z)
OFFERED DAILY Wildlife Wonders
At the Zoo’s Wegeforth Bowl amphitheater, wildlife care specialists will introduce you to wildlife ambassadors representing SDZWA’s conservation work around the world in Wildlife Wonders, presented daily at 2 p.m. Learn about amazing wildlife—from the Amazon to right here in our own backyard in San Diego. The presentation runs 15 to 20 minutes. (Z)
FOR MEMBERS
SEPTEMBER 10, OCTOBER 15
Member Exclusive Early Hours
Rise and shine with the sights and sounds of the San Diego Zoo. One Sunday each month, members can enter the Zoo one hour before the general public. To join us, simply present your membership card at the main entrance beginning at 8 a.m. (Z)
EVERY DAY
Wild Perks SM
San Diego Zoo Wildlife Alliance members are eligible for Wild Perks SM . Show your membership card each time you make an on-grounds purchase and save up to 20%, depending on your membership level. Some exclusions apply; for details, visit sdzwa.org/membership/ wild-perks (Z)
26 / SAN DIEGO ZOO WILDLIFE ALLIANCE JOURNAL / SEPTEMBER/OCTOBER 2023
September EVENTS
& October
SAFARI PARK
OFFERED DAILY
Journey into the Wild
Join our wildlife care specialist team as they introduce you to wildlife ambassadors representing SDZWA’s conservation work in our Amazonia Conservation Hub in South America, and right here in the Southwest. This new conservation presentation begins at 2 p.m. daily, at Benbough Amphitheater. (P)
OCTOBER 1–31
Kids Free
October is Kids Free month at the Safari Park, and youths ages 11 and younger receive free admission all month long. (P)
OCTOBER 9
Indigenous Peoples’ Celebration
The San Pasqual Band of Mission Indians is hosting the Indigenous Peoples’ Celebration at the Safari Park. This special event will include birdsinging, the creation story, other storytelling, and more. (P)
OCTOBER, SELECTED DATES
Supreme Roar & Snore Safari
The new Supreme Roar & Snore Safari— available on All Ages and Adults Only sleepovers—offers a whole new level of adventure at the Safari Park! You’ll soar into camp on the Flightline Safari zip line, take a Night Vision Safari to view wildlife through night vision binoculars, and later settle in for the evening in your own private tent. The next morning after breakfast, enjoy reserved VIP viewing of wildlife ambassador encounters, then take a Wildlife Safari through savanna habitats. Call 619-718-3000. (P)
SEPTEMBER AND OCTOBER, SELECTED DATES
Wildlife Safari: Sips on the Savanna
Enjoy craft beer among the wildlife of the African savanna! Begin with a “meet and greet” and a selection of craft beers. Next, board a covered, open-air safari truck and venture into an expansive habitat for up-close views of giraffes, antelope, and more. Then, it’s off to a breathtaking viewpoint for more craft beer and savory snacks, while taking in the sights and sounds of African wildlife. Ages 21 and older only. Book online or call 619-718-3000. (P)
SATURDAYS AND SUNDAYS IN OCTOBER
Autumn Festival
During Autumn Festival weekends in October, Safari Park guests can celebrate the fall season with fun educational and interactive experiences, and live country music. At Safari Park food locations, guests will find delectable tastes of autumn, available for a limited time only. On October 7, SDZWA members are invited to an Autumn Festival Member Preview. (P)

FOR MEMBERS
SEPTEMBER 10, OCTOBER 15
Member Exclusive Early Hours
Rise and shine with the sights and sounds of the Safari Park. One Sunday each month, members can enter the Safari Park one hour before the general public. To join us, simply present your membership card at the main entrance beginning at 8 a.m. (P)
EVERY DAY
Wild Perks SM
San Diego Zoo Wildlife Alliance members are eligible for Wild Perks SM . Show your membership card each time you make an on-grounds purchase and save up to 20%, depending on your membership level. Some exclusions apply; for details, visit sdzwa.org/ membership/wild-perks (P)
SAN DIEGO ZOO WILDLIFE ALLIANCE / SDZWA.ORG / 27
Nature Around You
Anyone can find, befriend, and protect nature as an ally for wildlife. Whether you live near a lush forest or in a bustling city, nature is all around you—you just have to look for it.
To practice finding nature around you, head outside to a space near your home, your neighborhood, or a park, and see if you can find wildlife that match the squares below. Once you do, mark off your square. The first person to connect three squares in a row is the winner!
Three different kinds of leaves


Two crawling insects
An animal web
An animal that lives in a nest or burrow

Two animals that fly
Two animal sounds
To grow the game for a larger group of friends, scan the QR code above to download Nature in Your Neighborhood Bingo Cards.
Something fluffy
Something yellow

the San Diego
Explorers
to find out about these
28 / SAN DIEGO ZOO WILDLIFE ALLIANCE JOURNAL / SEPTEMBER/OCTOBER 2023
Visit
Zoo Wildlife
website
and other animals, plus videos, crafts, stories, games, and more! SDZWildlifeExplorers.org
LAST LOOK
Also called the “bleeding heart baboon” because of the red patch on its chest, the gelada is the only grass-grazing monkey in the world. Males, like the one pictured, sport a long cape of hair on their backs. This species is also noted for its bipedal “shuffle gait.” Geladas can be seen in the Ethiopian Highlands habitat at the San Diego Zoo’s Africa Rocks.
Photographed by Ken Bohn, SDZWA photographer.

SAN DIEGO ZOO WILDLIFE ALLIANCE / SDZWA.ORG / 29
San Diego Zoo Wildlife Alliance
P.O. Box 120551, San Diego, CA 92112
You Can Help Save Wildlife.

You are our greatest ally as we work together to help protect and save wildlife. When you become a monthly donor, your reccurring gift fuels critical conservation efforts around the globe. Our monthly donors are the heartbeat of everything we do at San Diego Zoo Wildlife Alliance, and every sustaining gift adds up to make lasting impact for wildlife in need. You can inspire hope for wildlife worldwide and make a brighter future possible.
Become a Monthly Donor today at sdzwa.org/hero.

JOURNAL















































 BY DEBRA SHIER, PH.D., TALISIN HAMMOND, PH.D., SPENCER SIDDONS, PH.D, RON SWAISGOOD, PH.D., AND CANDACE WILLIAMS, PH.D.
BY DEBRA SHIER, PH.D., TALISIN HAMMOND, PH.D., SPENCER SIDDONS, PH.D, RON SWAISGOOD, PH.D., AND CANDACE WILLIAMS, PH.D.